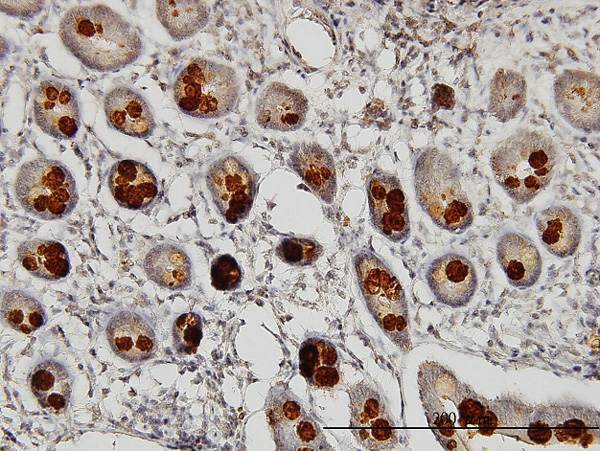

ABHD5 Antibody (monoclonal) (M01)
Mouse monoclonal antibody raised against a full length recombinant ABHD5.
- SPECIFICATION
- CITATIONS
- PROTOCOLS
- BACKGROUND

Application
| WB, IHC, E |
|---|---|
| Primary Accession | Q8WTS1 |
| Other Accession | BC021958 |
| Reactivity | Human, Rat |
| Host | mouse |
| Clonality | Monoclonal |
| Isotype | IgG2a Kappa |
| Clone Names | 1F3 |
| Calculated MW | 39096 Da |
| Gene ID | 51099 |
|---|---|
| Other Names | 1-acylglycerol-3-phosphate O-acyltransferase ABHD5, Abhydrolase domain-containing protein 5, Lipid droplet-binding protein CGI-58, ABHD5, NCIE2 |
| Target/Specificity | ABHD5 (AAH21958, 1 a.a. ~ 349 a.a) full-length recombinant protein with GST tag. MW of the GST tag alone is 26 KDa. |
| Dilution | WB~~1:500~1000 IHC~~1:100~500 E~~N/A |
| Format | Clear, colorless solution in phosphate buffered saline, pH 7.2 . |
| Storage | Store at -20°C or lower. Aliquot to avoid repeated freezing and thawing. |
| Precautions | ABHD5 Antibody (monoclonal) (M01) is for research use only and not for use in diagnostic or therapeutic procedures. |

Thousands of laboratories across the world have published research that depended on the performance of antibodies from Abcepta to advance their research. Check out links to articles that cite our products in major peer-reviewed journals, organized by research category.
info@abcepta.com, and receive a free "I Love Antibodies" mug.
Provided below are standard protocols that you may find useful for product applications.
Background
The protein encoded by this gene belongs to a large family of proteins defined by an alpha/beta hydrolase fold, and contains three sequence motifs that correspond to a catalytic triad found in the esterase/lipase/thioesterase subfamily. It differs from other members of this subfamily in that its putative catalytic triad contains an asparagine instead of the serine residue. Mutations in this gene have been associated with Chanarin-Dorfman syndrome, a triglyceride storage disease with impaired long-chain fatty acid oxidation.
References
1.Perilipins 2 and 3 lack a carboxy-terminal domain present in perilipin 1 involved in sequestering ABHD5 and suppressing basal lipolysis.Patel S, Yang W, Kozusko K, Saudek V, Savage DBProc Natl Acad Sci U S A. 2014 Jun 24;111(25):9163-8. doi: 10.1073/pnas.1318791111. Epub 2014 Jun 9.2.microRNA-29 fine-tunes the expression of key FOXA2-activated lipid metabolism genes and is dysregulated in animal models of insulin resistance and diabetes.Kurtz CL, Peck BC, Fannin EE, Beysen C, Miao J, Landstreet SR, Ding S, Turaga V, Lund PK, Turner S, Biddinger SB, Vickers KC, Sethupathy PDiabetes. 2014 Apr 10.3.Endurance Exercise Training Up-Regulates Lipolytic Proteins and Reduces Triglyceride Content in Skeletal Muscle of Obese Subjects.Louche K, Badin PM, Montastier E, Laurens C, Bourlier V, de Glisezinski I, Thalamas C, Viguerie N, Langin D, Moro CJ Clin Endocrinol Metab. 2013 Oct 31.4.Downregulation of adipose triglyceride lipase in the heart aggravates diabetic cardiomyopathy in db/db mice.Inoue T, Kobayashi K, Inoguchi T, Sonoda N, Maeda Y, Hirata E, Fujimura Y, Miura D, Hirano K, Takayanagi RBiochem Biophys Res Commun. 2013 Aug 16;438(1):224-9. doi: 10.1016/j.bbrc.2013.07.063. Epub 2013 Jul 22.5.Deficiency of Liver Comparative Gene Identification-58 (CGI-58) Causes Steatohepatitis and Fibrosis in Mice.Guo F, Ma Y, Kadegowda AK, Xie P, Liu G, Liu X, Miao H, Ou J, Su X, Zheng Z, Xue B, Shi H, Yu LJ Lipid Res. 2013 Jun 3.6.Cardiac-specific overexpression of perilipin 5 provokes severe cardiac steatosis via the formation of a lipolytic barrier.Pollak NM, Schweiger M, Jaeger D, Kolb D, Kumari M, Schreiber R, Kolleritsch S, Markolin P, Grabner GF, Heier C, Zierler KA, Rulicke T, Zimmermann R, Lass A, Zechner R, Haemmerle GJ Lipid Res. 2013 Apr;54(4):1092-102. doi: 10.1194/jlr.M034710. Epub 2013 Jan 23.7.PNPLA1 mutations cause autosomal recessive congenital ichthyosis in golden retriever dogs and humans.Grall A, Guaguere E, Planchais S, Grond S, Bourrat E, Hausser I, Hitte C, Le Gallo M, Derbois C, Kim GJ, Lagoutte L, Degorce-Rubiales F, Radner FP, Thomas A, Kury S, Bensignor E, Fontaine J, Pin D, Zimmermann R, Zechner R, Lathrop M, Galibert F, Andre C, Fischer J.Nat Genet. 2012 Jan 15;44(2):140-7. doi: 10.1038/ng.1056.8.Liver X Receptor (LXR) Regulates Human Adipocyte Lipolysis.Stenson BM, Ryden M, Venteclef N, Dahlman I, Pettersson AM, Mairal A, Astrom G, Blomqvist L, Wang V, Jocken JW, Clement K, Langin D, Arner P, Laurencikiene J.J Biol Chem. 2011 Jan 7;286(1):370-9. Epub 2010 Oct 28.9.B56{alpha}/Protein Phosphatase 2A Inhibits Adipose Lipolysis in High-Fat Diet-Induced Obese Mice.Kinney BP, Qiao L, Levaugh JM, Shao J.Endocrinology. 2010 Jun 9. [Epub ahead of print]
If you have used an Abcepta product and would like to share how it has performed, please click on the "Submit Review" button and provide the requested information. Our staff will examine and post your review and contact you if needed.
If you have any additional inquiries please email technical services at tech@abcepta.com.





Foundational characteristics of cancer include proliferation, angiogenesis, migration, evasion of apoptosis, and cellular immortality. Find key markers for these cellular processes and antibodies to detect them.
The SUMOplot™ Analysis Program predicts and scores sumoylation sites in your protein. SUMOylation is a post-translational modification involved in various cellular processes, such as nuclear-cytosolic transport, transcriptional regulation, apoptosis, protein stability, response to stress, and progression through the cell cycle.
The Autophagy Receptor Motif Plotter predicts and scores autophagy receptor binding sites in your protein. Identifying proteins connected to this pathway is critical to understanding the role of autophagy in physiological as well as pathological processes such as development, differentiation, neurodegenerative diseases, stress, infection, and cancer.